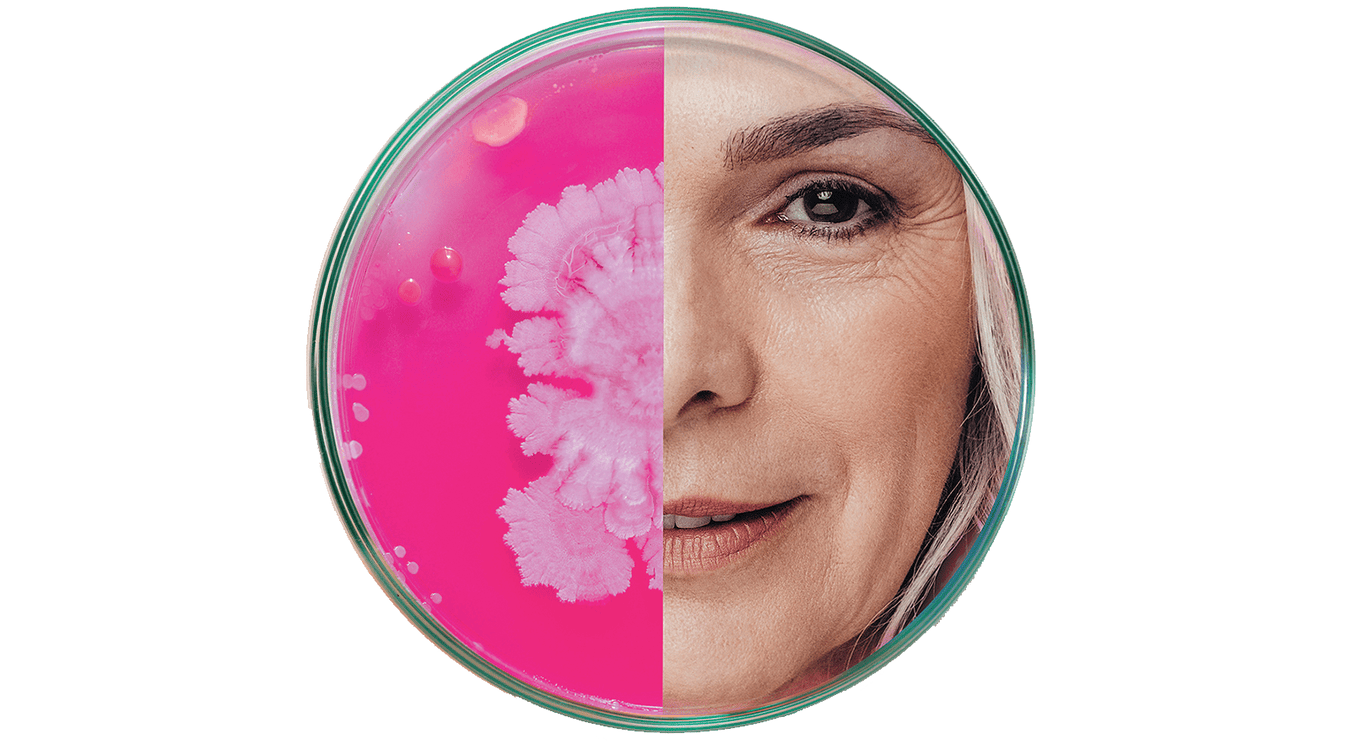
Foto: Esse Skincare

Artikel
Das Buzzword Diversität ist in aller Munde. In der Kosmetikbranche ist Vielfalt aber nicht nur ein Marketing-Begriff. Individuelle Behandlungen sind Standard – für jeden Hautzustand, Hautton, Geschlecht und Alter – und für Verbraucher ein Muss im Beauty-Jahr 2023.
BEAUTY FORUM Magazin
News Ticker
Anzeige
Produkthighlights
Artikel
Bedeutet das jüngste Urteil des Bundesarbeitsgerichts (BAG) das Ende der Vertrauensarbeitszeit? Rechtsanwalt Stefan Engels stellt das Urteil vor.
Artikel
Bessere Hautergebnisse lassen sich durch die Kombination von medizinischem Microneedlingund kosmetischen Vor- und Nachbehandlungen erzielen. Wie die Zusammenarbeit aus Medizinund Kosmetik aussieht, erfahren Sie hier.
Video
In dieser Folge geht der Beauty Business Coach näher auf die Summen- und Saldenliste ein. Beauty Business Coach Thomas Pretschner bietet Hilfe bei Business- und Finanzbegriffen für Kosmetikerinnen.
Seien Sie dabei und lernen Sie mit Leichtigkeit.
Anzeige
Artikel
Diese Gedanken sabotieren Sie und den Erfolg Ihres Instituts – Für dieses Phänomen gibt es auch Bezeichnungen wie Blackout, Tunnelblick oder Schock-starre. Sie kennen es vielleicht noch aus Ihrer Abschlussprüfung oder von der Verwaltung Ihrer letzten Kalkulation. Gerade als Unternehmerin ist es so wichtig, sich mögliche Gedankenblockaden bewusst zu machen, damit diese das eigene Wachstum und das des Geschäfts nicht sabotieren. Wie das geht, verrät Ihnen Business-Experte Semih Özbay.
Artikel
Mit wenig Aufwand neue Kunden gewinnen – Sie wollen den Instagram-Account Ihres Kosmetikinstituts aufs nächste Level heben, um damit möglichst viele Interessierte in Neukunden umzuwandeln? Klingt logisch, denn aktuell erreichen Sie Ihre Zielgruppe nirgends besser als auf Social Media. Jörg Sutara, Experte für Marketing im Mittelstand und Gründerthemen, hat Ihnen mit diesem Leitfaden für die aufmerksamkeitsstarke Positionierung Ihres Kanals die wichtigsten Punkte zusammengestellt.
Artikel
Mehr Empfehlungen dank einer gelungenen Customer Journey – Positives Kundenfeedback kurbelt das Empfehlungsmarketing an und gilt in der Word-of-Mouth getriebenen Kosmetikbranche als der entscheidende Schlüssel zum Erfolg. Neben den persönlichen Kontaktpunkten treten für Institutsinhaber auch digitale Kanäle immer mehr in den Vordergrund. Welche Faktoren auf die Kundenzufriedenheit einzahlen und an welchen Stellen Investitionen Sinn ergeben, lesen Sie in diesem Fachartikel.
Anzeige
Artikel
Effektiv für die eigenen Produkte und Anwendungen werben – Beim Surfen durch das Internet begegnen uns an den verschiedensten Stellen Werbeanzeigen. Für Sie als Unternehmerin können diese die Chance darstellen, mit Ihren Services und Produkten auf den vorderen Rängen der Suchergebnisse zu landen. Wie Sie das Thema angehen, weiß Online-Marketingspezialist Andreas Karasek.
Artikel
Als Kosmetikerin online Geld verdienen – Besonders die Krisenzeit hat uns bewiesen, dass eine zweite Einnahmequelle Gold wert sein kann. Als Expertin bietet Ihnen die Beauty-Branche eine Reihe von Möglichkeiten, sich online etwas aufzubauen und dazuzuverdienen. Beauty Business Coach Antje Meyer weiß, welche das sind, denn sie ist ihren Weg hin zum digitalen Arbeiten bereits gegangen. Im Folgenden hat sie Ihnen einige Hinweise und Tipps zusammengestellt.
Artikel
Wie Sie sich und Ihr Institut für die Pension vorbereiten und dabei noch Steuern sparen – Das Ende Ihrer beruflichen Laufbahn steht Ihnen kurz bevor und Sie fragen sich nun, ob Sie an alles gedacht haben. Schließlich soll Ihnen Ihre Rente ausreichen, damit Sie Ihren Ruhestand ge-nießen können und gut über die Runden kommen. Wie Sie Ihren Berufsausstieg und den Verkauf Ihres Instituts steuerlich möglichst günstig gestalten, weiß Steuerberater und Rechtsanwalt Dietrich Loll.
Anzeige
Artikel
Institutskalkulation 2023: Endlich wieder Überblick über Ihre Zahlen – Was wäre, wenn Institute in Zukunft nur noch ihre lukrativsten und liebsten Behandlungen anbieten, ihre eigenen Zahlen verstehen und wissen, dass ihre Preise fair und richtig kalkuliert sind? Beauty Business-Expertin Andrea Hurt-Gläser weiß, dass das möglich ist, und hat ihre Tipps für Sie in diesem Beitrag zusammengetragen.
Artikel
Apparative Beauty-Treatments sind längst gelebte Praxis. Doch damit eine Behandlung auch den gewünschten Effekt hat, ist es wichtig, währenddessen auch die richtigen Produkte und Präparate einzusetzen: Denn nicht jedes apparative Treatment lässt sich gleich gut mit jedem Präparat kombinieren.
Anzeige
Artikel
Was verbirgt sich hinter dem Begriff „Cosmeceuticals“? Er ist die Kombination von Cosmetic und Pharmaceutical, also Kosmetik plus medizinische Wirkstoffe. Die Idee ist nicht ganz neu: Bereits vor langer Zeit entdeckte man, dass medizinische Wirkstoffe auch einen kosmetischen Nutzen haben können.
Artikel
Die Haut ist zwar ein sehr widerstandsfähiges Organ, gleichzeitig ist sie aber auch sehr sensibel. Sie reagiert beispielsweise auf unsere mentale Gesundheit, psychischen Stress oder unterdrückte Wut mit Pickeln, rissiger Haut oder Herpes. Die ganzheitliche Kosmetikerin Jessica Luft erklärt anhand von drei Hautsymptomen die mögliche psychosomatische Bedeutung dahinter und wie Sie von einer ganzheitlichen Betrachtungsweise profitieren können.
Artikel
In der modernen Kosmetik geht es nicht mehr darum, die Hautalterung zu stoppen, sondern der Fokus liegt auf der Hautgesundheit. Mit welchen Maßnahmen die Hautqualität möglichst lang erhalten werden kann, erfahren Sie hier.
Artikel
Interview: Florian Panholzer, stellvertretender Direktor Hotel Zugspitze, Garmisch-Partenkirchen – Per Klick zur Massage: Umsatzsteigerungen und eine hohe Akzeptanz seitens der Gäste sind erfreuliche Konsequenzen, die für die schnelle Umsetzung eines Digitalkonzepts sprechen. Der stellvertretende Hoteldirektor Florian Panholzer hat sich des Themas angenommen. Seit Kurzem kommen digitale Buchungshelfer auch im Wellnessbereich erfolgreich zum Einsatz. Wir wollten mehr darüber erfahren und haben mit Herrn Panholzer über die Umsetzung und seine Zukunftsvisionen gesprochen.
Artikel
Die Verleihungszeremonie der Golden Globes erfolgt im Rahmen einer Gala in Los Angeles, zu der geladen ist, wer in Hollywood Rang und Namen hat. Doch auch Sie können handwerklich von der Kraft der „Golden Globes“ als Wellnesswärmekugeln profitieren und für Ihre Kunden damit eine wunderbare Fuß-/Beinmassage kreieren, die es auf die große Bühne schafft und Ihren Kunden somit einen besonderen Kopfkino-Moment schenkt.
Artikel
Es mag Menschen geben, die das Alter ignorieren, die Natur tut es nicht. Wenn der Mensch älter wird, läuft eine Vielzahl an Prozessen im Körper ab. Nur ein kleiner Teil der Hautalterung ist auf intrinsische Faktoren zurückzuführen, die kaum beeinflussbar sind. Entsprechend unterschiedlich ist die Qualität der Hautalterung je nach exogenen Einflüssen.
Video
Wie genau der Zusammenhang aus investiertem Kapital und gezieltem Gewinn ist und was der Begriff Return on Investment damit zu tun hat, erklärt unser Beauty Business Coach in dieser Folge. Beauty Business Coach Thomas Pretschner bietet Hilfe bei Business- und Finanzbegriffen für Kosmetikerinnen. Seien Sie dabei und lernen Sie mit Leichtigkeit.
Artikel
Bei dem Wort „Ballast“ haben wir Bilder von einem schweren Koffer, von Ballaststeinen in alten Segelschiffen oder seelischer Belastung im Kopf. Dabei sollten uns Ballaststoffe ein Lächeln ins Gesicht zaubern – denn sie belasten überhaupt nicht, sondern übernehmen wichtige Aufgaben im Körper.
Artikel
Farben und Formen: Hier kommen die Nageltrends 2023. Animiert von neuen Schnitten, Farben und Styles für das nahende Frühjahr, wirft Beauty Forum einen Blick auf die Nageldesigntrends für das noch neue Jahr, die Sie ab sofort in Ihrem Studio umsetzen können.
Artikel
Die Haut als größtes Organ im Körper bildet die eine Schnittstelle zwischen innen und außen. Sie erfüllt eine wichtige Schutzfunktion, die sogenannte Barrierefunktion, die es zu schützen gilt. Negative Umwelteinflüsse oder Stress schwächen diese Barrierefunktion und machen die Haut durchlässig für pathogene Mikroben. In der Folge reagiert die Haut sensibel, gereizt und altert schneller.
Artikel
Sie lieben Ihren Beruf als Kosmetikerin? Sie können sich nichts Schöneres vorstellen, als noch lange Ihre Kunden zu verwöhnen? Dann passen Sie gut auf sich auf, denn die gebückte und lange sitzende Haltung während der Behandlung belastet Ihren Rücken enorm. Gymnastiklehrerin Marianne Nick erklärt Ihnen, wie Sie Ihren Rücken während und zwischen den Behandlungen entlasten können.
Artikel
Deshalb sollten Sie Ihre Institutsorganisation digital abwickeln – Das Potenzial der Digitalisierung wird auch in der Kosmetikbranche immer mehr genutzt. Das gilt für die Institute genauso wie für deren Kunden. Die Digitalisierung schreitet in großen Schritten voran und macht auch vor Kosmetikinstituten nicht halt: Kunden buchen ihre Termine immer häufiger online, angerufen wird immer seltener.
Artikel
Tipps zur Verbesserung Ihrer Rhetorik bei Vorträgen – Sei es bei einer Veranstaltung, bei einem Seminar, vor Ihren Angestellten oder digital, in Ihren regelmäßigen Insta Stories: Als Kosmetikerin haben Sie immer mal wieder die Gelegenheit, eine Rede zu halten. Damit Sie künftig noch selbstsicherer vor Publikum sprechen, teilt Managementberaterin und Vortragsrednerin Barbara Liebermeister in diesem Beitrag die wichtigsten Tipps zum Planen und Halten von Vorträgen, die beim Publikum ankommen.
Artikel
So finden Talente und Stellen im Kosmetikinstitut zueinander – Neben dem Mangel an qualifizierten Fachkräften gibt es einen weiteren Grund, warum einige Stellen in Instituten länger unbesetzt bleiben. Die Ausschreibungen sind zu starr: Titel, Aufgabenbeschreibung und Anforderungsprofil. Andererseits wird nach der „eierlegenden Wollmilchsau“ gesucht – natürlich mit Erfahrung. Was Sie tun können, um die passenden Bewerber und damit neue Mitarbeiter zu finden, lesen Sie in den folgenden Abschnitten.
Artikel
Durch Kleidung zu mehr Selbstbewusstsein und einer besseren Außenwirkung – Sie wollen in, aber auch außerhalb Ihres Instituts positiv wahrgenommen werden? Nicht selten kommt es vor, dass neue Geschäftsbeziehungen auf Messen, Tagungen und Veranstaltungen entstehen. Stylistin und Visual Brander Swetlana Posdnyschewa weiß, worauf es bei der Wahl der richtigen Kleidung ankommt. Erfahren Sie in diesem Artikel, welche Auswirkungen unsere Kleiderwahl auf unser Umfeld und uns selbst hat.